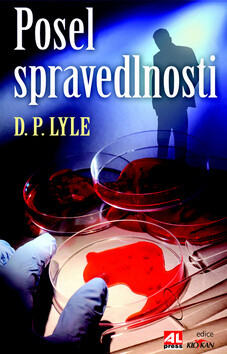
Posel spravedlnosti - D. P. Lyle

0.0 z 5 hvězdiček
knihaKniha ( pevná vazba )
- Produkt je vyprodaný.
Dub Walker vyšetřoval stovky zločinů, ohledávalzohavené ostatky obětí brutálních vražd, a protose domníval, že v jeho profesi ho už nic nepřekvapí.Ovšem když je zavražděn jeho blízký přítel,vše je jinak. Vrah jako by se mu vysmíval, jehobrutalita roste s každou další obětí. Walker nastražína pachatele past, ale to, co v ní uvízne, mudoslova… Přejít na celý popis
K tomuto produktu zákazníci kupují
-
Hranice spravedlnosti

-
AKCE Talisman: Harry Potter

-
Šťastné hororové mládí

-
AKCE Mizející dívky

-
Poslední důkaz

-
Harry Potter: Rok v Bradavicích

-
10 ZA 500,- Za úsvitu

-
Bestseller Elektronická dárková poukázka 200 Kč

5.0 z 5 hvězdiček
Voucher -
Dívka beze jména

-
Sběratel trofejí

-
Poškozená Spící spravedlnost (poškozená)

-
Dívka v ledu

-
Bestseller Nevyměkni

-
Bezcitně

-
10 ZA 500,- Měla umřít

-
Sladké pokušení

-
AKCE Půlnoční hostina

-
10 ZA 500,- Osud

-
Šéf

-
10 ZA 500,- Dvakrát do stejné řeky

-
AKCE Neskutečná

-
Stíny minulosti

-
AKCE Skutečná

-
AKCE Beze strachu

Dub Walker vyšetřoval stovky zločinů, ohledávalzohavené ostatky obětí brutálních vražd, a protose domníval, že v jeho profesi ho už nic nepřekvapí.Ovšem když je zavražděn jeho blízký přítel,vše je jinak. Vrah jako by se mu vysmíval, jehobrutalita roste s každou další obětí. Walker nastražína pachatele past, ale to, co v ní uvízne, mudoslova vyrazí dech…
- série
- Dub Walker 1. díl z 2
- Další ze série
-
1.
Posel spravedlnosti
2. Hranice důvěry
- kategorie
-
Knihy »
Beletrie »
Detektivky, Thrillery a Horory »
Thrillery
- Témata
- Přidat téma
- Nakladatel
- Alpress
- Rozměr
- 138 x 209 x 31
- isbn
- 978-80-7466-175-4
- Vazba
- pevná vazba
- datum vydání
- 1.07.2013
- ean
- 9788074661754
- Počet stran
- 176
- jazyk
- čeština
Hodnocení a recenze čtenářů Nápověda
0.0 z 5 0 hodnocení čtenářů
0× 5 hvězdiček 0× 4 hvězdičky 0× 3 hvězdičky 0× 2 hvězdičky 0× 1 hvezdička
Přidejte své hodnocení knihy
Vývoj ceny Nápověda
Získejte přehled o vývoji ceny za posledních 60 dní.
Články, které stojí za pozornost
-

-

-

-

-

-

-

-

-

-

-

-

KnihyDobrovsky.cz
KnihyDobrovsky.cz
 knihydobrovsky
knihydobrovsky
 @knihydobrovskycz
@knihydobrovskycz
 @knihydobrovsky
@knihydobrovsky



